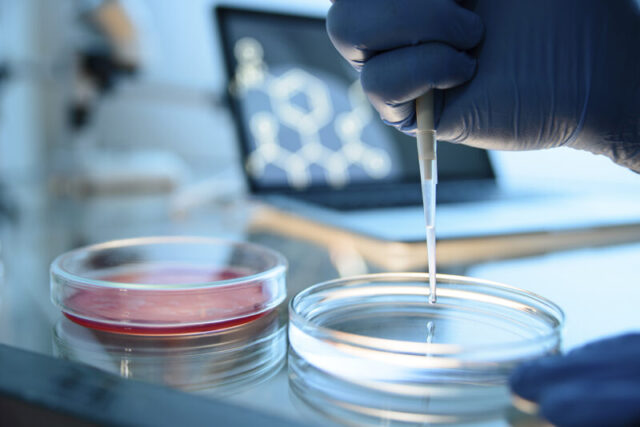
Тверская межобластная ветеринарная лаборатория выиграла межлабораторные испытания Тверская межобластная ветеринарная лаборатория выиграла межлабораторные испытания

В связи с сильным ухудшением погодных условий в филиале «Россети Центр» — «Тверьэнерго» введён особый режим работы. В настоящее время Тверская область находится под влиянием атлантического циклона...
В данном разделе мы публикуем важные новости и события, которые происходят у наших партнеров и друзей портала tverlife.ru
В новогоднюю ночь тверичи поздравляли друзей и близких при помощи интернета: используя мессенджеры и видеосвязь. Объем трафика после полуночи вырос на 25% по сравнению...
12 января 2022 года сотрудниками отдела фитосанитарного надзора, качества зерна и семенного контроля Управления Россельхознадзора по Тверской и Ярославской областям было проведено фитосанитарное контрольное...
В 2021 году абоненты стационарной телефонии «Ростелекома» в Верхневолжье совершили более 50 млн исходящих вызовов и проговорили свыше 2,5 млн часов. По сравнению с...
На сегодняшний день объем просроченной дебиторской задолженности перед «Россети Центр» — «Тверьэнерго», накопленной потребителями городов Нелидово, Андреаполь, Торопец, Западная Двина в зоне исполнения филиалом...
Указом Президента Российской Федерации № 525 от 10.09.2021 года за заслуги в области энергетики и многолетнюю добросовестную работу почетного звания «Заслуженный энергетик Российской Федерации»...
В июне 2020 года Управлением Россельхознадзора по Тверской и Ярославской областям было вынесено четыре постановления о привлечении к административной ответственности гражданина Российской Федерации в...
Tele2 расширил список бесплатных услуг для абонентов, находящихся в Казахстане. Роумеры могут бесплатно звонить в Россию и Казахстан, отправлять SMS до 19 января включительно. Особые условия действуют...
Даниил Каримов, управляющий директор сектора металлургии аналитического управления «Открытие Research». Котировки энергетического угля 11 января 2022 г. в Европе (API2) выросли на 15% до $135/т, в Азии (Newcastle)...
ФГБУ «Тверская МВЛ» в очередной раз подтвердило свою компетентность и профессионализм специалистов, участвуя в межлабораторных сравнительных испытаниях. Так, сотрудники отдела безопасности и качества животноводческой и...